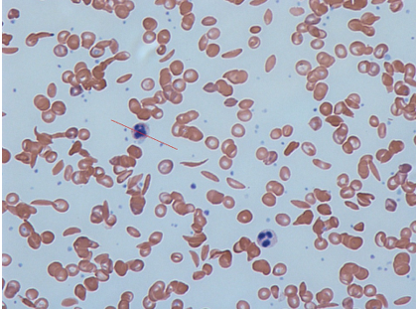

Review | DOI: https://doi.org/10.31579/2834-5126/121
Is it Possible to Eliminate Sickle Cell Disease (SCD) among Indian Tribes?
- Shanti Lal Choubisa 1,2*
1Department of Advanced Science and Technology, National Institute of Medical Science and Research, NIMS University Rajasthan, Jaipur, Rajasthan 303121, India.
2Former Department of Zoology, Government Meera Girls College, MLS University, Udaipur, Rajasthan 303002, India.
*Corresponding Author: Shanti Lal Choubisa, Department of Propaedeutics of Internal Medicine, Grodno State Medical University, Grodno, Belarus.
Citation: Shanti L. Choubisa, (2025), Is it Possible to Eliminate Sickle Cell Disease (SCD) among Indian Tribes? Clinical Trials and Clinical Research,4(6); DOI:10.31579/2834-5126/121
Copyright: © 2025, Shanti Lal Choubisa. This is an open access article distributed under the creative commons’ attribution license, which permits unrestricted use, distribution, and reproduction in any medium, provided the original work is properly cited.
Received: 03 November 2025 | Accepted: 20 November 2025 | Published: 10 December 2025
Keywords: elimination; heterozygotes; homozygotes; malaria; red cell genetic disorders; sickle cell anaemia (sca); sickle cell disease (scd); sickle genes; tribes
Abstract
Sickle cell disease (SCD) is a genetic blood-borne disease that is inherited from one generation to the next in humans and is most common in young people. This fatal disease causes anaemia; hence it is also called sickle cell anaemia (SCA). The disease also causes pain crises, stunted growth and affects multiple organs such as the lungs, heart, kidneys, eyes, bones and brain. The disease is the result of a "point mutation" in the haemoglobin (Hb) gene located on autosome 11. People suffering from this disease do not survive long and it becomes more severe with age. The disease is endemic in geographical areas where malaria is prevalent. In India, the disease is endemic and widespread, mainly in tribal areas and among various tribal communities. In the country, the gene of this disease (HB-S) is found in 0-18% of the tribals of Northeast India, 0-33.5% in Western India, 1-40% in Southern India and 22.5-44.4% in Central India, while its frequency has been found to be between 0.31-0.41%. This disease is not only affecting the entire life of the tribals in the country, but is also causing them huge economic losses. This disease causes morbidity and mortality among the tribals, therefore, the Ministry of Health and Family Welfare, Government of India has taken a comprehensive and challenging step to eliminate this disease as a public health problem by 2047 through the “National Sickle Cell Anaemia Elimination Mission” launched on 1st July 2023. To eliminate SCD, the main focus of this mission is on identification, management, prevention, and awareness. Presently, as on 18.03.2025, about 5.11 crore persons in the age group of 0-40 years have been screened in 278 SCD affected tribal districts and 1,91,103 SCD (Hb-SS) cases and 13,73,597 carriers (Hb-AS) have been identified in a short period. If this mission continues at the same pace and works sincerely, it is possible to completely eliminate the spread of this disease from Indian tribes or reduce its prevalence. However, its success rate depends on certain factors, which have been focused upon in this communication. Also, the author has drawn attention to the social problem created in the tribal communities due to this mission, which has also been highlighted.
Introduction
During human evolution, under the pressure of certain environmental or biological factors, many types of red blood cell genetic disorders have also developed due to mutations in genes. In the human population, the most common of these red blood cell genetic disorders are abnormal or mutated haemoglobin, thalassemia, and G-6-PD enzyme deficiency (GD). Some of these blood disorders lead to serious diseases that can even kill humans. These blood genetic disorders are limited or widely spread in human populations depending on specific geographical or environmental regions. In humans, the genes for these genetic disorders are usually found in heterozygous and homozygous states. However, they may also exist in double-heterozygous state, but this is rare. When the genes for certain genetic disorders, such as sickle cell haemoglobin (Hb-S) and β-thalassaemia, are found in homozygous state, they pose serious threats to human health and cause varying degrees of morbidity and mortality in human population. These genetic disorders are also called 'killers' and the genes for these red blood cell disorders are commonly called 'lethal genes'. Interestingly, these erythrocyte mutant genes are also regional and population-specific. Genes for Hb-S, β-thalassemia, and Gd are more prevalent in malaria-affected areas and tribal people [1-17]. It is well known, malaria is fatal, caused by infection with Plasmodium falciparum-malaria parasite. According to the recently released World Malaria Report, 2022 by the WHO [18], thousands of people die due to malaria every year worldwide. The interesting thing is that the malaria parasite and its carriers and the tribal people have been living together for thousands of years or centuries and are still living together, yet the tribal people are alive and safe from malaria infection. After all, how do these tribal people avoid malaria and remain safe? Actually, this has been possible in these tribal people only through natural selection [19-23]. Perhaps this is an amazing, unique, and rare example of human biological development or evolution. In fact, malaria itself is an important biological factor responsible for this natural selection in tribals [24-26]. During biological evolution, under the pressure of this malarial strain caused mutations in the β-polypeptide or globin gene on chromosome 11 associated with human erythrocytes or red blood cells, leading to the formation of Hb-S in these cells [27]. Due to this, the blood cells become sickle- shaped (Figures 1 and 2). These mutated β-globin genes, also known as sickle cell genes, are inherited from one generation to the other among the tribals, which is still present in them today. These sickle cell genes are responsible and capable of protecting these tribals from deadly malaria [28-41]. In addition to the sickle cell gene, some other genes for red cell genetic disorders, such as Hb-C, β-thalassaemia, glucose-6-phosphate dehydrogenase (G-6-PD) deficiency (Gd), and certain blood groups are also found for genetic resistance to malaria in human populations [42-53]. But sickle genes are found in large numbers among the tribals of India, due to which thousands of tribal men and women are suffering from sickle cell disease (SCD). This disease is not only fatal but is also weakening the economic condition of the tribals. Therefore, the Medical and Health Department of the Government of India has started a mission (National Sickle Cell Anaemia Elimination Mission) on 1st July 2023 to eliminate or reduce the prevalence of this disease in the tribals across the country. In this contemporary review, apart from the cause and prevalence of this disease, special attention has been paid to whether it is possible to eradicate or reduce the prevalence of this disease among the tribals through this mission run by the Medical and Health Department of the Government of India. The factors responsible for its success have also been highlighted, which can prove to be more important and useful as suggestions. In this review, the author has also drawn attention to a serious social problem arising among the tribals due to this mission, which needs to be considered.

Figure 1: Erythrocytes (red blood cells) are normally round and flexible. But in sickle cell disease, some of the red blood cells take on a sickle-shaped appearance called sickle cells.
Cause of sickle cell disease (SCD)
It is well known that in humans, synthesis of sickle cell haemoglobin (Hb-S) is the result of a single base-pair point mutation (GAG to GTG) in the β-polypeptide or globin gene located on chromosome 11. This genetic mutation is responsible for the substitution of the amino acid glutamic acid for valine
at the sixth position of the β-chain of haemoglobin (β6Glu→Val), the resulting haemoglobin (Hb) is called sickle cell haemoglobin or Hb-S which was discovered by Herrick in 1910 in a black student from the West Indies [27]. His blood film revealed the presence of sickle-shaped erythrocytes or sickle cells (Figure 2).
Figure 2: Blood film of a SCD patient, showing both normal (spherical) and sickle-shaped erythrocytes.
The gene responsible for Hb-S synthesis is called the sickle cell gene. Heterozygotes have mutations in only one of the two β-globin chains, resulting in sickle cell trait (Hb-AS). Homozygous individuals (Hb-SS) have mutations in both β-globin chains, resulting in "sickle cell disease" (SCD). When deoxygenated, Hb-S distorts erythrocytes from a bulging disc to a crescent or "sickle" shape. This change in shape damages erythrocyte membrane, leading to premature destruction of these blood cells and chronic haemolytic anaemia. Sickled erythrocytes can obstruct blood flow and cause tissue hypoxia, which can lead to severe ischemic pain or even stroke. Sickle cell patients also have functional asplenia and are at increased risk of recurrent infections [54, 55]. Patients develop anaemia due to sickle cell disease, hence the term "sickle cell anaemia"(SCA). In addition to pain, the disease also causes growth retardation, and affects many organs of patients such as lungs, heart, kidneys, eyes, bones, and brain. The disease worsens with age and often leads to death in the absence of effective treatment.
Sickle cell genes in tribals
Sickle cell genes appear in humans according to Mendel's laws of inheritance. Sickle cell gene alleles are usually found in two forms, heterozygous (AS) and homozygous (SS). In the population, those who are AS heterozygous have genes for both normal Hb (Hb-A) and sickle cell haemoglobin (Hb-S) and these people live like normal individuals but they are carriers of SCD and are therefore commonly called "carriers". These carriers are usually protected from malaria. But SS homozygotes have SS alleles and these people develop an inherited haemolytic disease called SCD (SCA). There is no cure for most people with SCD. Treatments can only relieve pain and help prevent complications associated with the disease. “According to Mendel's laws of inheritance, if a normal person marries a carrier (heterozygotes), then 50% of their children are likely to be normal and 50% will be carriers. Similarly, if carriers marry then 25% of their children are likely to be normal, 25% will be SCD patients and 50% will be carriers. If two people with SCD get married, all their children will also have the disease”. The prevalence of the sickle cell gene varies considerably across regions, but reaches up to 40% in some areas of sub-Saharan Africa, eastern Saudi Arabia, and central India [3,4]. Among diverse Indian tribes the prevalence of the sickle cell gene has been found to range from 0 to 44%. In the country, the sickle cell gene among tribal communities is found to be 0-18% in Northeast India, 0-33.5% in Western India, 1-40% in Southern India and 22.5-44.4% in Central India and its frequency varies between 0.31-0.41% [3,4,56]. Tribal groups with a high prevalence of the sickle cell gene (20-35%) include the Bhils, Madias, Pawaras, Pradhans and Otakars [2,4]. In India, apart from tribal individuals, sickle cell genes have also been in subjects belonging to the Scheduled Castes (SC), Other Backward Castes (OBC) and minorities, including Muslim, Bohra-Muslim, and Jain communities [ 57-65].
Sickle cell disease among Indian tribes
In the country, tribal people are facing several types communicable and non-communicable diseases and environmental issues [66-92]. But sickle cell disease (SCD) is more dangerous and ultimately causes death among tribal people. Individuals with this have reduced life expectancy. A recent study estimated the life expectancy of adults with SCD to be 54 years, approximately 20 years shorter than that of adults without SCD [93, 94]. This genetic disease is not only responsible for morbidity and mortality among the tribals but also causes huge economic loss to the tribals as well as has a profound impact on their living standards. India has the second highest prevalence of sickle cell disease in the world, with 1 in 86 births having sickle cell disease (SCD). The exact information or authentic statistical data about how many tribals are dying every year due to this disease in the country is still not available. However, the Ministry of Health & Family Welfare, Government of India is very serious and concerned about this disease among these poor tribal people. Therefore, the Government of India has decided to eliminate or reduce the spread of this disease among the tribes living in different areas of the country. For this, the “National Sickle Cell Anaemia Elimination Mission- 2023” (NSCAEM -2023) was launched by the Hon'ble Prime Minister of India on 1st July 2023. To eliminate SCD (SCD) among tribals, the main focus of this mission is on identification, management, prevention and awareness. Presently, as on 18.03.2025, about 5.11 crore tribal persons aged 0-40 years have been screened in 278 SCD affected tribal districts and 1,91,103 SCD cases and 13,73,597 carriers (Hb-AS) have been identified in the short term [95]. Interestingly, in a one-year survey in the state of Rajasthan, a total of 10,746 tribal individuals from Rajsamand, Chittorgarh, Pali, Sirohi, Dungarpur, Banswara, Pratapgarh, Baran, and Udaipur districts were screened for evidence of SCD. Of these, 2,980 (27.73%) individuals were diagnosed with the SCD and 7,766 (72.26%) showed early symptoms of this disease. Out of the 2,980 individuals, 1590 (%) were women [96]. These initial figures are very surprising and full of achievements in a short time, which are extremely important and useful in the elimination of this dangerous disease. It is clear from these figures that testing of tribal people living in various tribal areas of the country should be necessary and mandatory. Such surveys can reveal the real status of the number of patients and carriers of this disease, which can help in preventing it.
Treatment of SCD
Generally, in the country, most of the tribal people are economically very poor, uneducated, orthodox, and superstitious and have deep faith in their local deities and believe that these will keep them healthy. Tribal people usually use herbs and also use their traditional methods to treat various diseases. One of these methods is cruel, horrible, and painful. In this, they brand the forehead, hands, legs, back, and stomach of the patient with a hot iron rod for treatment. Although this method does not cure the patient, sometimes the patient dies due to secondary infection. No specific treatment or medicine has been developed yet to treat this disease, which means that this disease is still incurable. But the main aim of managing this disease is to avoid pain attacks, relieve symptoms, and prevent complications and infections. Lifestyle, vaccinations, and immunizations can also reduce the severity of this disease. Its treatment may also include medicines (hydroxyurea, L-glutamine oral powder, crizanlizumab, antibiotics, etc.) and blood transfusions. In some children and adolescents, bone marrow and stem cell transplants may offer the possibility of curing the disease. Gene therapies are also being developed that may provide a cure for people suffering from SCD. But these therapies are so expensive that they are difficult to make available to all patients.
Is it possible to eliminate SCD among Indian tribes?
All these treatments for SCD are very expensive and cannot be availed by every poor tribal patient. However, there is no guarantee that these treatments will cure the disease. That is why the only cure for this disease is prevention. For this, it is very important to prevent the disease from passing on to the next generation. “For this, it is necessary that the persons who have the genes of this disease should neither marry nor have physical relations, that is, neither between the carriers of this disease nor between its patients. This is possible by developing awareness and genetic counselling. If the foetus of such persons has this disease, then abortion of such a foetus is the right and effective way to eliminate or reduce the prevalence of this disease”. Therefore, it is very important to first identify the carriers and patients of this disease, which is being done under the NSCAEM- 2023. The success of this mission depends on detecting the carriers and patients of this disease through screening by genetic or recommended test in the shortest possible time.
The government is committed to eradicate this disease before the Amrit Kaal of India in 2047. Undoubtedly, it is possible to eradicate or reduce the prevalence of SCD through this mission. But it is too early to say how much time it will take. However, for the success of this mission, it is also important to pay attention to the following suggestions or points: -
- Apart from screening of tribal people aged 0-40 years for this disease, unborn babies should also be screened for this disease in tribal areas. For this, genetic testing facility for this disease should be available in every tribal district hospital.
- Establishment of separate and well-equipped laboratories in Primary Health Centres (PHCs) or district hospitals so that every tribal can easily reach these laboratories and get their SCD tested. If the disease is confirmed, there should be a provision for free treatment of the patient at these hospitals.
- Appointment of well-qualified, honest, and dedicated medical officers, technical or laboratory staff, and genetic counsellors in these hospitals is also vital for the success of this mission.
- Genetic counsellors should behave in a friendly, brotherly, and affinity manner towards carriers and patients of this disease. They should be able to convince them that those who carry the genes for this disease should not marry each other.
- There is a need to monitor the mission to ensure there is no misuse of funds and corruption.
- To ensure that there is no shortage of funds for the smooth running of the mission, the government should allocate a special budget as per the need.
- The responsibility of carrying out this mission should be vested only in the hands of able and energetic people who have adequate experience in administration and management.
- Proper monitoring of this mission time to time is also essential. There is also a need to run an awareness campaign about this disease among the tribal people and school children.
Social problem among tribals caused by NSCAEM-2023
There is no doubt that NSCAEM-2023 being run by the government in tribal areas is a positive and laudable step towards the eradication of this deadly sickle cell disease. But it has also given rise to a new social problem in the tribal communities which needs to be addressed. “Although this genetic disease does not discriminate on the basis of gender, the identification of this disease is now creating discrimination among tribal people which needs to be considered. Because this mission reveals the identity of the carriers and patients of SCD. This identification has started creating a feeling of discrimination among the families of tribals. Recently it has been observed that no one likes to marry the members of the family in which carriers and/ or patients of this disease are present. Whereas normal people are also found in such families.” What form this social problem of discrimination will take in the future is in the womb of the future. But to solve this problem, along with this mission, there is a need to formulate a strategy from now itself, otherwise this social problem can take a serious form in the near future which can also have adverse consequences. Therefore, it should not be ignored.
Conclusions
Sickle cell disease (SCD) is a genetic and fatal disease that is inherited from generation to generation. Usually, the disease is endemic in malaria-affected areas. India ranks second in the world in terms of SCD, where 1 in every 86 children suffers from SCD. The disease is mainly prevalent in the tribal communities of the country and thousands of tribals are suffering from this disease and lakhs of people are also carriers of it. There is also no exact cure for this disease. Therefore, prevention of this disease is the only treatment. SCD is not only causing morbidity and mortality among the tribals but also affecting their lifestyle and economic condition. Therefore, the Ministry of Health and Family Welfare, Government of India has initiated its elimination program in the tribal areas of the country through National Sickle Cell Anaemia Elimination Mission- 2023. Under this, 5.11 crore tribal people in the age group of 0-40 years were screened in a short period and 1,91,103 SCD cases and 13,73,597 carriers (HB-AS) were identified. If this mission continues at the same pace with honesty and there is no misuse of money and corruption in it, then there is no doubt that the spread of this disease in the tribal communities of the country can be eliminated or reduced. But the social discrimination that is developing among the people due to this mission also needs attention. People often do not like to marry members of a family in which this disease or carrier is present, which is regrettable.
Acknowledgements
The author thanks to Dr Darshana Choubisa, Professor, Department Prosthodontics, Geetanjali Dental and Research Institute Udaipur 313002, Rajasthan, India and Dr Pallavi Choubisa, Assistant Professor, Department of Obstetrics and Gynaecology, RNT Medical College and Pannadhay Zanana Hospital, Udaipur 313002, Rajasthan, India for cooperation.
References
- Nagel RL, Roth Jr EF. (1989). Malaria and red cell genetic defects.74(4):1213-1221. Blood; 74 (4): 1213–1221.
View at Publisher | View at Google Scholar - Bhatia HM, Rao VR. (1987). Genetic Atlas of India. Institute of Immunohaematology, Indian Council of Medical Research, Seth GS Medical College, Bombay, India.
View at Publisher | View at Google Scholar - Kar BC, Devi S, Dash KC, Das M. (1987). The sickle cell gene is widespread in India. Trans Royal Soc Trop Med Hyg; 81(2):273-275.
View at Publisher | View at Google Scholar - Colah RB, Mukherjee MB, Martin S, Ghosh K. (2015). Sickle cell disease in tribal populations in India. Indian J Med Res; 141(5):509-515.
View at Publisher | View at Google Scholar - Jain RC, Andrew AMR, Choubisa SL, Acharya A, Joshi KC. (1983). Sickle cell gene in the Mina tribal population of Kherwara tehsil of Udaipur district in Rajasthan. Indian J Med Res; 78: 522-555.
View at Publisher | View at Google Scholar - Jain RC, Andrew AMR, Choubisa SL. (1983). Sickle cell and thalassaemic genes in tribal population of Rajasthan. Indian J Med Res; 78: 836-840.
View at Publisher | View at Google Scholar - Jain RC, Choubisa SL, Acharya A, Andrew AMR, Chhaparwal JK, et al. (1983). Incidence of G-6-PD deficiency in the tribal population of southern Rajasthan. J Assoc Physicians India;32(3):266-267.
View at Publisher | View at Google Scholar - Choubisa SL. (1988). Abnormal haemoglobins, thalassaemia and G-6-PD deficiency in school children belonging to scheduled castes and tribes of Rajasthan, India. Indian J Physic Anthrop Human Genet;14(3):31-40.
View at Publisher | View at Google Scholar - Choubisa SL. (1990). Sickle cell traits in Damor tribe of Dungarpur district, southern Rajasthan. Man in India;70(4):454-458.
View at Publisher | View at Google Scholar - Choubisa SL, Choubisa DK, Choubisa L. (2004). Erythrocyte genetic disorders in inhabitants of Aravali hilly environment. Indian J Physic Anthrop Human Genet; 23(2): 145-159.
View at Publisher | View at Google Scholar - Choubisa SL. (2009). Sickle cell haemoglobin, thelassaemia and G-6-PD enzyme deficiency genes in Garasiya tribe inhabited malaria endemic areas of Sirohi district, Rajasthan (India). J Commun Dis; 41(1):13-18.
View at Publisher | View at Google Scholar - Mohanty SS, Parihar S, Had RK, Toteja GS, Sharma AK. (2022). Prevalence of sickle cell anemia, β-thalassemia and glucose-6-phosphate dehydrogenase deficiency among the tribal population residing in the Aravali hills of Sirohi region of Rajasthan state. Clinic Epidemiol Global Health; 13: 100916
View at Publisher | View at Google Scholar - El-Hazmi MA, Al-Hazmi AM, Warsy AS. (2011). Sickle cell disease in Middle East Arab countries. Indian J Med Res;134(5):597-610.
View at Publisher | View at Google Scholar - Saraf SL, Molokie RE, Nouraie M, Sable CA, Luchtman-Jones L, et al. (2014). Differences in the clinical and genotypic presentation of sickle cell disease around the world. Paediatr Respir Rev. 15(1):4-12.
View at Publisher | View at Google Scholar - Choubisa SL, Choubisa A. (2021). A brief review of sickle-cell haemoglobin, β-thalassaemia and G-6-PD deficiency genes among tribals of scheduled area of Rajasthan, India: focus on tribal health. J Biomed Res Environ Sci; 2(12): 1187-1196.
View at Publisher | View at Google Scholar - Dixit S, Das A, Rana R, Khuntia HK, Ota AB , et al. (2022). Community-based study on haemoglobinopathies and G6PD deficiency among particularly vulnerable tribal groups in hard-to-reach malaria endemic areas of Odisha, India: implications on malaria control. Malaria J; 21,340.
View at Publisher | View at Google Scholar - Mohanty SS, Purohit A, Anand PK, Huda RK, Sharma AK. (2022). Burden of sickle cell disease in tribal students in Maa-Baadi institutions in southern Rajasthan - A pilot study. Indian J Med Res; 156:269-274
View at Publisher | View at Google Scholar - WHO. (2022). World malaria report. World Health Organization, Geneva. pp1-133.
View at Publisher | View at Google Scholar - Allison AC. (1954). Protection afforded by sickle-cell trait against sub tertian malarial infection. British Med J; 4857:290–294.
View at Publisher | View at Google Scholar - Choubisa SL, Sharma PN, Parmar L. (1984). Haemoglobin-A2 and glucose-6-phosphate dehydrogenase deficiency in relation to malaria. Indian J Parasitol; 8(2): 247-249.
View at Publisher | View at Google Scholar - Choubisa SL. (1985). Sickle cell haemoglobin, glucose-6-phosphate dehydrogenase deficiency and thalassaemic genes in relation to malaria endemicity. Indian J Parasitol; 9(2):131-133.
View at Publisher | View at Google Scholar - Choubisa SL, Choubisa A. (2021). Status of erythrocyte genetic disorders in people of desert and humid environments, Rajasthan, India: focus on natural selection in tribals against malaria. Proc Indian Natl Sci Acad; 87(3): 433-445.
View at Publisher | View at Google Scholar - Choubisa SL. (2023). How do sickle cell genes protect tribal people from deadly malaria? Is this a type of natural selection? Annals of Hematol Oncol; 10(5):1-6, id1437.
View at Publisher | View at Google Scholar - Haldane JBS. (1932). The causes of evolution. London: Longmans Green & Co.
View at Publisher | View at Google Scholar - Haldane JBS. (1949). Disease and evolution. Ricerca Scientif;19(Suppl I):68-76.
View at Publisher | View at Google Scholar - Esoh K, Wonkam A. (2021). Evolutionary history of sickle-cell mutation: implications for global genetic medicine. Human Mol Genet; 30(1):119-128.
View at Publisher | View at Google Scholar - Herrick JB. (1910). Peculiar elongated and sickle-shaped red blood corpuscles in a case of severe anaemia. Archi Internal Med (Chic); 6(5):517-521.
View at Publisher | View at Google Scholar - Luzzatto L, Nwachuku-Jarrett ES, Reddy S. (1970). Increased sickling of parasitised erythrocytes as mechanism of resistance against malaria in the sickle-cell trait. Lancet; i:319-321.
View at Publisher | View at Google Scholar - Friedman MJ. (1978). Erythrocytic mechanism of sickle cell resistance to malaria. Proc Natl Acad Sci USA; 75:1994-1997.
View at Publisher | View at Google Scholar - Guggenmoos-Holzmann I, Bienzle U, Luzzatto L. (1981). Plasmodium falciparum malaria and human red cells. II. Red cell genetic traits and resistance against malaria. Intl J Epidemiol; 10:16-22.
View at Publisher | View at Google Scholar - Choubisa SL. (1985). Sickle cell haemoglobin, glucose-6-phosphate dehydrogenase deficiency and thalassaemic genes in relation to malaria endemicity. Indian J Parasitol;9(2):131-133.
View at Publisher | View at Google Scholar - Luzzatto L, Pinching AJ. (1990). Commentary to R Nagel -innate resistance to malaria: the intra erythrocytic cycle. Blood Cells; 16:340-347.
View at Publisher | View at Google Scholar - Choubisa SL. (1991). Abnormal haemoglobins, thalassaemia and G-6-PD enzyme deficiency in Rajasthan (Western-India). Haematologia; 24(3):153-165.
View at Publisher | View at Google Scholar - Olumese PE, Adeyemo AA, Ademowo OG, Gbadegesin RA, Sodeinde O, et al. (1997). The clinical manifestations of cerebral malaria among Nigerian children with the sickle cell trait. Annals Trop Paediatr; 17:141-145.
View at Publisher | View at Google Scholar - Aidoo M, Terlouw DJ, Kolczak MS, McElroy PD, Ter Kuile FO, et al. (2002). Protective effects of the sickle cell gene against malaria morbidity and mortality. Lancet; 359:1311-1312.
View at Publisher | View at Google Scholar - Williams TN, Mwangi TW, Roberts DJ, Alexander ND, Weatherall DJ, et al. (2005). An immune basis for malaria protection by the sickle cell trait. PLoS Med; 2: e128.
View at Publisher | View at Google Scholar - Williams TN. (2006). Human red blood cell polymorphisms and malaria. Curr Opin Microbiol; 9:388-394.
View at Publisher | View at Google Scholar - Cholera R, Brittain NJ, Gillrie MR, Lopera-Mesa TM, Diakite SA, et al. (2008). Impaired cytoadherence of Plasmodium falciparum-infected erythrocytes containing sickle hemoglobin. Proce Natl Acad of Sci USA;105: 991-996.
View at Publisher | View at Google Scholar - Ferreira A, Marguti I, Bechmann I, Jeney V, Chora A, et al. (2011). Sickle hemoglobin confers tolerance to Plasmodium infection. Cell; 145:398-409.
View at Publisher | View at Google Scholar - Gong L, Maiteki-Sebuguzi C, Rosenthal PJ, Hubbard AE, Drakeley CJ, et al. (2012). Evidence for both innate and acquired mechanisms of protection from Plasmodium falciparum in children with sickle cell trait. Blood; 119:3808-14.
View at Publisher | View at Google Scholar - Luzzatto L. (2012). Sickle cell anaemia and malaria. Mediterranean J Hematol Infect Dise; 4(1): e2012065.
View at Publisher | View at Google Scholar - Luzzatto L, Usanga EA, Reddy S. (1969). Glucose -6-phosphate dehydrogenase deficient red cells: resistance to infection by malarial parasites. Science; 164:839-42.
View at Publisher | View at Google Scholar - Choubisa SL, Sharma PN, Parmar L. (1984). Haemoglobin-A2 and glucose-6-phosphate dehydrogenase deficiency in relation to malaria. Indian J Parasitol;8(2):247-249.
View at Publisher | View at Google Scholar - Miller LH, Mason SJ, Dvorak JA, McGinniss MH, Rothman IK. (1975). Erythrocyte receptors for (Plasmodium knowlesi) malaria: Duffy blood group determinants. Science; 189:561-563.
View at Publisher | View at Google Scholar - Modiano D, Luoni G, Sirima BS, Simpore J, Verra F, Konate A, et al. (2001). Haemoglobin C protects against clinical Plasmodium falciparum malaria. Nature; 414:305-308.
View at Publisher | View at Google Scholar - Ayi K, Turrini F, Piga A, Arese P. (2004). Enhanced phagocytosis of ring-parasitized mutant erythrocytes: a common mechanism that may explain protection against falciparum malaria in sickle trait and beta-thalassemia trait. Blood; 104:3364-33871.
View at Publisher | View at Google Scholar - Choubisa SL, Choubisa DK, Choubisa L. (2005). The ABO blood groups and malaria. J Parasit Dis;29(2):109-11.
View at Publisher | View at Google Scholar - Choubisa SL, Choubisa DK, Khare S. (2000). α-thelassaemia (Hb-Bart’s) in Rajasthan (India). Haematologia, 30(3): 209-213.
View at Publisher | View at Google Scholar - Choubisa SL, Choubisa DK, Choubisa L. (2003) Focus on red cell genetic defects and malaria. J Parasit Dis; 27(2): 99-103.
View at Publisher | View at Google Scholar - Verra F, Simpore J, Warimwe GM, Tetteh KK, Howard T, Osier FH, et al. (2007). Haemoglobin C and S role in acquired immunity against Plasmodium falciparum malaria. PLoS One; 2: e978.
View at Publisher | View at Google Scholar - Danquah I, Ziniel P, Eggelte TA, Ehrhardt S, Mockenhaupt FP. (2010). Influence of haemoglobins S and C on predominantly asymptomatic Plasmodium infections in northern Ghana. Trans Royal Soc Trop Med Hyg; 104:713-719.
View at Publisher | View at Google Scholar - Choubisa SL. (2010). Haemoglobin-C gene in India? Curr Sci; 99(7): 860.
View at Publisher | View at Google Scholar - Achoubi N, Asghar M, Meitei SY, Sachdeva MP, Sarawathy et al. (2010). Haemoglobinopathies and glucose-6-phosphate dehydrogenase deficiency in a malaria endemic region of Manipur, northeast India. Anthropol Sci;118 (3): 201-204.
View at Publisher | View at Google Scholar - Forget BG, Bunn HF. (2013). Classification of the Disorders of Hemoglobin. Cold Spring Harbor Perspect Med ;3(2): a011684.
View at Publisher | View at Google Scholar - Kato GJ, Piel FB, Reid CD, Gaston MH, Ohene-Frempong K, Krishnamurti L, et al. (2018). Sickle cell disease. Nat Rev Dis Primers; 4: 18010.
View at Publisher | View at Google Scholar - Gorakshakar AC. (2012). Epidemiology of sickle haemoglobin in India. Proceeding of National Symposium on Tribal Health, Indian Council of Medical Research, New Delhi, India. pp103-108.
View at Publisher | View at Google Scholar - Choubisa SL, Parmar L, Purohit VK. (1984). Abnormal haemoglobins in subjects belonging to scheduled castes of Udaipur district (Rajasthan). Indian J Med Res; 80: 463-468.
View at Publisher | View at Google Scholar - Choubisa SL. (1985). Erythrocyte glucose-6-phosphate dehydrogenase deficiency and thalassaemic genes in schedule castes of Rajasthan. Indian J Med Res; 82: 554-558.
View at Publisher | View at Google Scholar - Choubisa SL, Parmar L, Chouhan MB, Sharma SL. (1986). Sickle cell trait in scheduled castes of Rajasthan. Indian J Pathol Microbiol; 29:386-390.
View at Publisher | View at Google Scholar - Choubisa SL, Choubisa L, Pande S, Srivastava YK. (1987). Incidence of abnormal haemoglobins and G-6-PD deficiency in school children of Udaipur (Rajasthan), India. J Trop Medic Hyg; 90:215-216.
View at Publisher | View at Google Scholar - Choubisa SL, Choubisa L, Pande S, Bhatt DK. (1987). Abnormal haemoglobins, thalassaemia and G-6-PD deficiency in Suthar community of southern Rajasthan. Indian J Physic Anthrop Human Genet; 14(3):9-16.
View at Publisher | View at Google Scholar - Choubisa SL. (1990). Distribution of Hb-Bart’s (α-thalassaemia) in various population of Dungarpur district of Rajasthan (India). Indian J Physic Anthrop Human Genet; 6(1&2):43-48.
View at Publisher | View at Google Scholar - Choubisa SL, Choubisa DK. (1994). Erythrocyte glucose-6-phosphate dehydrogenase deficiency in senile cataracts. Man in India; 74(3):267-270.
View at Publisher | View at Google Scholar - Choubisa SL. (2003). Erythrocyte genetic disorders in subject belonging to general castes and other backward castes of Aravali hilly region of Rajasthan (India). Indian J Physic Anthrop Human Genet; 22(1):33-43.
View at Publisher | View at Google Scholar - Choubisa SL, Choubisa L. (2006). Erythrocyte mutant genes in inhabitants of arid environment of Western-Rajasthan (India). Indian J Physic Anthrop Human Genet; 25(1):45-50.
View at Publisher | View at Google Scholar - Choubisa SL, Choubisa L. (1992). Prevalence of intestinal and malaria parasitic infections in tribal students of Dungarpur (Rajasthan). Indian J Parasitol;16(2):55-57.
View at Publisher | View at Google Scholar - Choubisa SL, Choubisa L. (2005). Trichomonas veginalis parasitic infection (Trichomoniasis) in subjects inhabiting rural environment of tribal region of southern Rajasthan. J Parasit Dis; 29(1):77-80.
View at Publisher | View at Google Scholar - Choubisa SL, Choubisa L. (2006). Intestinal helminthic infections in tribal population of southern Rajasthan, India. J Parasit Dis;30(2):163-167.
View at Publisher | View at Google Scholar - Choubisa SL. (2009). Amoebiasis among tribals of Rajasthan (India). J Commun Dis; 41(1):53-55.
View at Publisher | View at Google Scholar - Choubisa SL, Verma R, Choubisa L. (2010). Dracunculiasis in tribal region of Rajasthan (India): A case report. J Parasit Dis; 34(2): 94-96.
View at Publisher | View at Google Scholar - Choubisa SL. (2010). Snails as bio-indicators for dreaded trematodiasis diseases. J Communi Dis; 42(3): 223-226.
View at Publisher | View at Google Scholar - Choubisa SL, Jaroli VJ, Choubisa P, Mogra N. (2012). Intestinal parasitic infection in Bhil Tribe of Rajasthan, India. J Parasit Dis; 36(2):143-148.
View at Publisher | View at Google Scholar - Choubisa SL, Jaroli VJ. (2013). Gastrointestinal parasitic infections in diverse species of domestic ruminants inhabiting tribal rural areas of southern Rajasthan, India. J Parasit Dis; 37(2):271-275.
View at Publisher | View at Google Scholar - Choubisa SL. (2022). A historical dreaded human nematode parasite, Dracunculus worm (Dracunculus medinensis) whose awe is still alive in elderly of India! Can't it reappear in India? Austin Pub Health; 6(1): 1-4, id1019.
View at Publisher | View at Google Scholar - Choubisa SL, Choubisa P. (2024). Are freshwater sources safe for the health of humans and domestic animals in terms of deadly trematodiases? Med Disco; 3(1):1102.
View at Publisher | View at Google Scholar - Choubisa SL. (2024). Can gastrointestinal parasitic infections be eliminated among tribal people in India? Yes, this can happen with sustained effective efforts. Clinic Laborat Res; 2(2):1-7.
View at Publisher | View at Google Scholar - Choubisa SL, Choubisa P. (2024). Mortality in neonate bats infested by ectoparasite bugs in India; humans are at risk too. Environ Pub Health Res; 2(1):1778.
View at Publisher | View at Google Scholar - Choubisa SL. (2025). Invasion of giant African snail species (Achatina fulica) in scheduled area of Rajasthan, India: threat to forestry, agriculture and horticulture. Clinic Res Anim Sci; 3(5):1-6.
View at Publisher | View at Google Scholar - Choubisa SL, Choubisa DK, Joshi SC, Choubisa L. (1997). Fluorosis in some tribal villages of Dungarpur district of Rajasthan, India. Fluoride; 30(4):223-228.
View at Publisher | View at Google Scholar - Choubisa SL. (1999). Chronic fluoride intoxication (fluorosis) in tribes and their domestic animals. Intl J Environ Stud; 56(5):703-716.
View at Publisher | View at Google Scholar - Choubisa SL. (2001). Endemic fluorosis in southern Rajasthan (India). Fluoride; 34(1): 61-70.
View at Publisher | View at Google Scholar - Choubisa SL. (2012). Fluoride in drinking water and its toxicosis in tribals, Rajasthan, India. Proc Natl Acad Sci, India Sect B: Biol Sci; 82(2): 325-330.
View at Publisher | View at Google Scholar - Choubisa SL, Choubisa D. (2015). Neighbourhood fluorosis in people residing in the vicinity of superphosphate fertilizer plants near Udaipur city of Rajasthan (India). Environ Monit Assess 187(8):497.
View at Publisher | View at Google Scholar - Choubisa SL, Choubisa D. (2016). Status of industrial fluoride pollution and its diverse adverse health effects in man and domestic animals in India. Environ Sci Poll Res; 23(8):7244-7254.
View at Publisher | View at Google Scholar - Choubisa SL. (2018). A brief and critical review of endemic hydrofluorosis in Rajasthan, India. Fluoride; 51(1):13-33.
View at Publisher | View at Google Scholar - Choubisa SL. (2022). Status of chronic fluoride exposure and its adverse health consequences in the tribal people of the scheduled area of Rajasthan, India. Fluoride; 55(1): 8-30.
View at Publisher | View at Google Scholar - Choubisa SL, Choubisa D, Choubisa A. (2023). Fluoride contamination of groundwater and its threat to health of villagers and their domestic animals and agriculture crops in rural Rajasthan, India. Environ Geochem Health; 45:607-628.
View at Publisher | View at Google Scholar - Choubisa SL. (2024). Focus on dangerous skeletal fluorosis, how it can be prevented in humans. Pol; Commun Health Effects. 2(2):1-7.
View at Publisher | View at Google Scholar - Choubisa SL. (2024). A brief review of fluoride-induced bone disease skeletal fluorosis in humans and its prevention. J Pharmaceut Pharmacol Res; 7(8):1-6.
View at Publisher | View at Google Scholar - Choubisa SL. (2025). A brief review of fluoride exposure and its adverse health effects among tribal children in India. J Clinic Med Health Care; 2(2):1-9.
View at Publisher | View at Google Scholar - Choubisa SL. (2025). Risk of fluorosis and other health hazards in humans from coal-fired brick kilns in India: People need to be aware. Clinical Medical Reviews and Reports. 7(1): 1-7.
View at Publisher | View at Google Scholar - Choubisa SL. (2025). Are coal-based thermal power plants safe for human health in case of fluoride poisoning in India? people need to be careful and alert. Clinic Med Rev Report; 7(3):1-7.
View at Publisher | View at Google Scholar - Lubeck D, Agodoa I, Bhakta N, Danese M, Pappu K, et al. (2019). Estimated life expectancy and income of patients with sickle cell disease compared with those without sickle cell disease. JAMA Network Open.; 2(11): e1915374.
View at Publisher | View at Google Scholar - ASH (American Society of Hematology). (2023). Quantifying the life expectancy gap for people living with sickle cell disease.
View at Publisher | View at Google Scholar - MHFW (Ministry of Health & Family Welfare). (2025). National Sickle Cell Anaemia Elimination Mission- 2023 (NSCAEM-2023), Department of Health & Family Welfare, Government of India, New Delhi, India.
View at Publisher | View at Google Scholar - Dainik Bhashkar. (2025). 19746 people from 9 tribal districts are suffering from deadly blood disease sickle cell, Government warns - do not marry each other (news).6th Feb, 2025, 248:7, dainikbhashakar.com.
View at Publisher | View at Google Scholar
Clinic